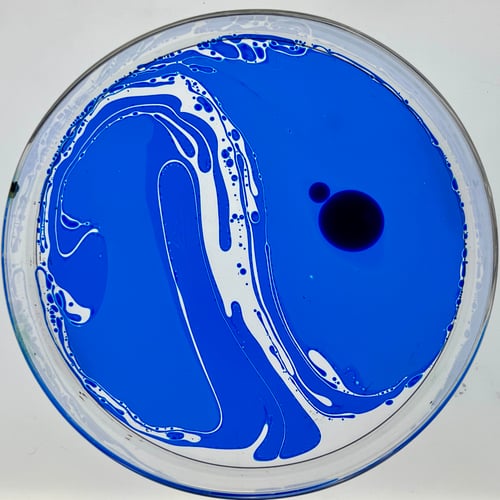
Image of Expansion Colors - Set of All 6 - Save$

Expansion Colors - Set of All 6 - Save$
$89.00 On Sale
Save $6 with this package!Set of all 6 all expansion colors.
Featuring:
- "Raspberry" - a juicy shade of reddish-violet
- "Emerald" - a lucky green which is a bit lighter and warmer than our classic 'Green' or 'Limpid Green'
- "Cobalt" - a new blue which is a bit richer and a shade darker than our classic 'Blue' or 'Blue Cheer'
- "Sienna" - a reddish-brown with copper overtones
- "Coffee" - a deliciously smooth and creamy brown
- "Graphite" - a grey with a dark blue bias, which becomes black after a few extra drops
These are superior quality, transparent dyes for use in liquid light shows or fluid art. They mix easily with mineral oil, and float well on top of water, creating classic psychedelic blobs and swirly patterns.
*Dyes are concentrated, and only require a few drops*
Non-toxic, vegetable based formula. 1 oz glass bottle, with dropper top.------------------------------------------------------------------------
SHIPPING WORLDWIDE! Please allow 2 weeks shipping (U.S. orders) Shipping times for orders outside US depend on local customs offices.
**If expedited shipping is needed, please email me to arrange! **
*NYC area folks, I am located in Manhattan and local pick up is available. This saves on shipping and tax. Email to arrange!
Questions? Email: [email protected]